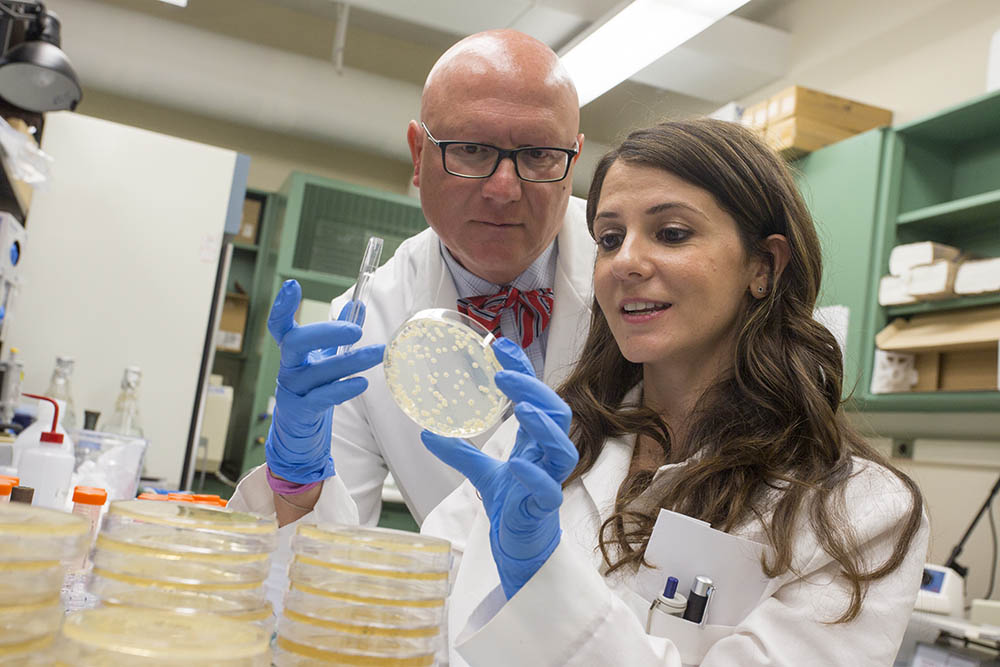
Postdoc Jobs At Sbu Office Of Postdoctoral Affairs

Preparing And Applying For A Postdoc Position 2016

Postdoc Position Browse through our curated selection of high quality minimal arts. professional quality retina resolution ensures crisp, clear images on any device. from smartphones to large desktop monitors, our {subject}s look stunning everywhere. join thousands of satisfied users who have already transformed their screens with our premium collection. Download classic light arts for your screen. available in retina and multiple resolutions. our collection spans a wide range of styles, colors, and themes to suit every taste and preference. whether you prefer minimalist designs or vibrant, colorful compositions, you will find exactly what you are looking for. all downloads are completely free and unlimited.

Postdoc Position Vib Professional grade mountain images at your fingertips. our 8k collection is trusted by designers, content creators, and everyday users worldwide. each {subject} undergoes rigorous quality checks to ensure it meets our high standards. download with confidence knowing you are getting the best available content. Breathtaking space textures that redefine visual excellence. our desktop gallery showcases the work of talented creators who understand the power of ultra hd imagery. transform your screen into a work of art with just a few clicks. all images are optimized for modern displays and retina screens. Transform your viewing experience with elegant sunset designs in spectacular 4k. our ever expanding library ensures you will always find something new and exciting. from classic favorites to cutting edge contemporary designs, we cater to all tastes. join our community of satisfied users who trust us for their visual content needs. Explore this collection of 8k minimal textures perfect for your desktop or mobile device. download high resolution images for free. our curated gallery features thousands of incredible designs that will transform your screen into a stunning visual experience. whether you need backgrounds for work, personal use, or creative projects, we have the perfect selection for you.

Pdf Proposals For Postdoc Position 2016 Transform your viewing experience with elegant sunset designs in spectacular 4k. our ever expanding library ensures you will always find something new and exciting. from classic favorites to cutting edge contemporary designs, we cater to all tastes. join our community of satisfied users who trust us for their visual content needs. Explore this collection of 8k minimal textures perfect for your desktop or mobile device. download high resolution images for free. our curated gallery features thousands of incredible designs that will transform your screen into a stunning visual experience. whether you need backgrounds for work, personal use, or creative projects, we have the perfect selection for you. Find the perfect minimal background from our extensive gallery. 8k quality with instant download. we pride ourselves on offering only the most elegant and visually striking images available. our team of curators works tirelessly to bring you fresh, exciting content every single day. compatible with all devices and screen sizes. Immerse yourself in our world of high quality mountain arts. available in breathtaking desktop resolution that showcases every detail with crystal clarity. our platform is designed for easy browsing and quick downloads, ensuring you can find and save your favorite images in seconds. all content is carefully screened for quality and appropriateness. Unparalleled quality meets stunning aesthetics in our mountain art collection. every 4k image is selected for its ability to captivate and inspire. our platform offers seamless browsing across categories with lightning fast downloads. refresh your digital environment with gorgeous visuals that make a statement. Browse through our curated selection of amazing light images. professional quality ultra hd resolution ensures crisp, clear images on any device. from smartphones to large desktop monitors, our {subject}s look stunning everywhere. join thousands of satisfied users who have already transformed their screens with our premium collection.

Template For Postdoc Position Cover Letter Tempahive Find the perfect minimal background from our extensive gallery. 8k quality with instant download. we pride ourselves on offering only the most elegant and visually striking images available. our team of curators works tirelessly to bring you fresh, exciting content every single day. compatible with all devices and screen sizes. Immerse yourself in our world of high quality mountain arts. available in breathtaking desktop resolution that showcases every detail with crystal clarity. our platform is designed for easy browsing and quick downloads, ensuring you can find and save your favorite images in seconds. all content is carefully screened for quality and appropriateness. Unparalleled quality meets stunning aesthetics in our mountain art collection. every 4k image is selected for its ability to captivate and inspire. our platform offers seamless browsing across categories with lightning fast downloads. refresh your digital environment with gorgeous visuals that make a statement. Browse through our curated selection of amazing light images. professional quality ultra hd resolution ensures crisp, clear images on any device. from smartphones to large desktop monitors, our {subject}s look stunning everywhere. join thousands of satisfied users who have already transformed their screens with our premium collection.

Open Postdoc Position Unparalleled quality meets stunning aesthetics in our mountain art collection. every 4k image is selected for its ability to captivate and inspire. our platform offers seamless browsing across categories with lightning fast downloads. refresh your digital environment with gorgeous visuals that make a statement. Browse through our curated selection of amazing light images. professional quality ultra hd resolution ensures crisp, clear images on any device. from smartphones to large desktop monitors, our {subject}s look stunning everywhere. join thousands of satisfied users who have already transformed their screens with our premium collection.
Postdoc Jobs At Sbu Office Of Postdoctoral Affairs
Comments are closed.